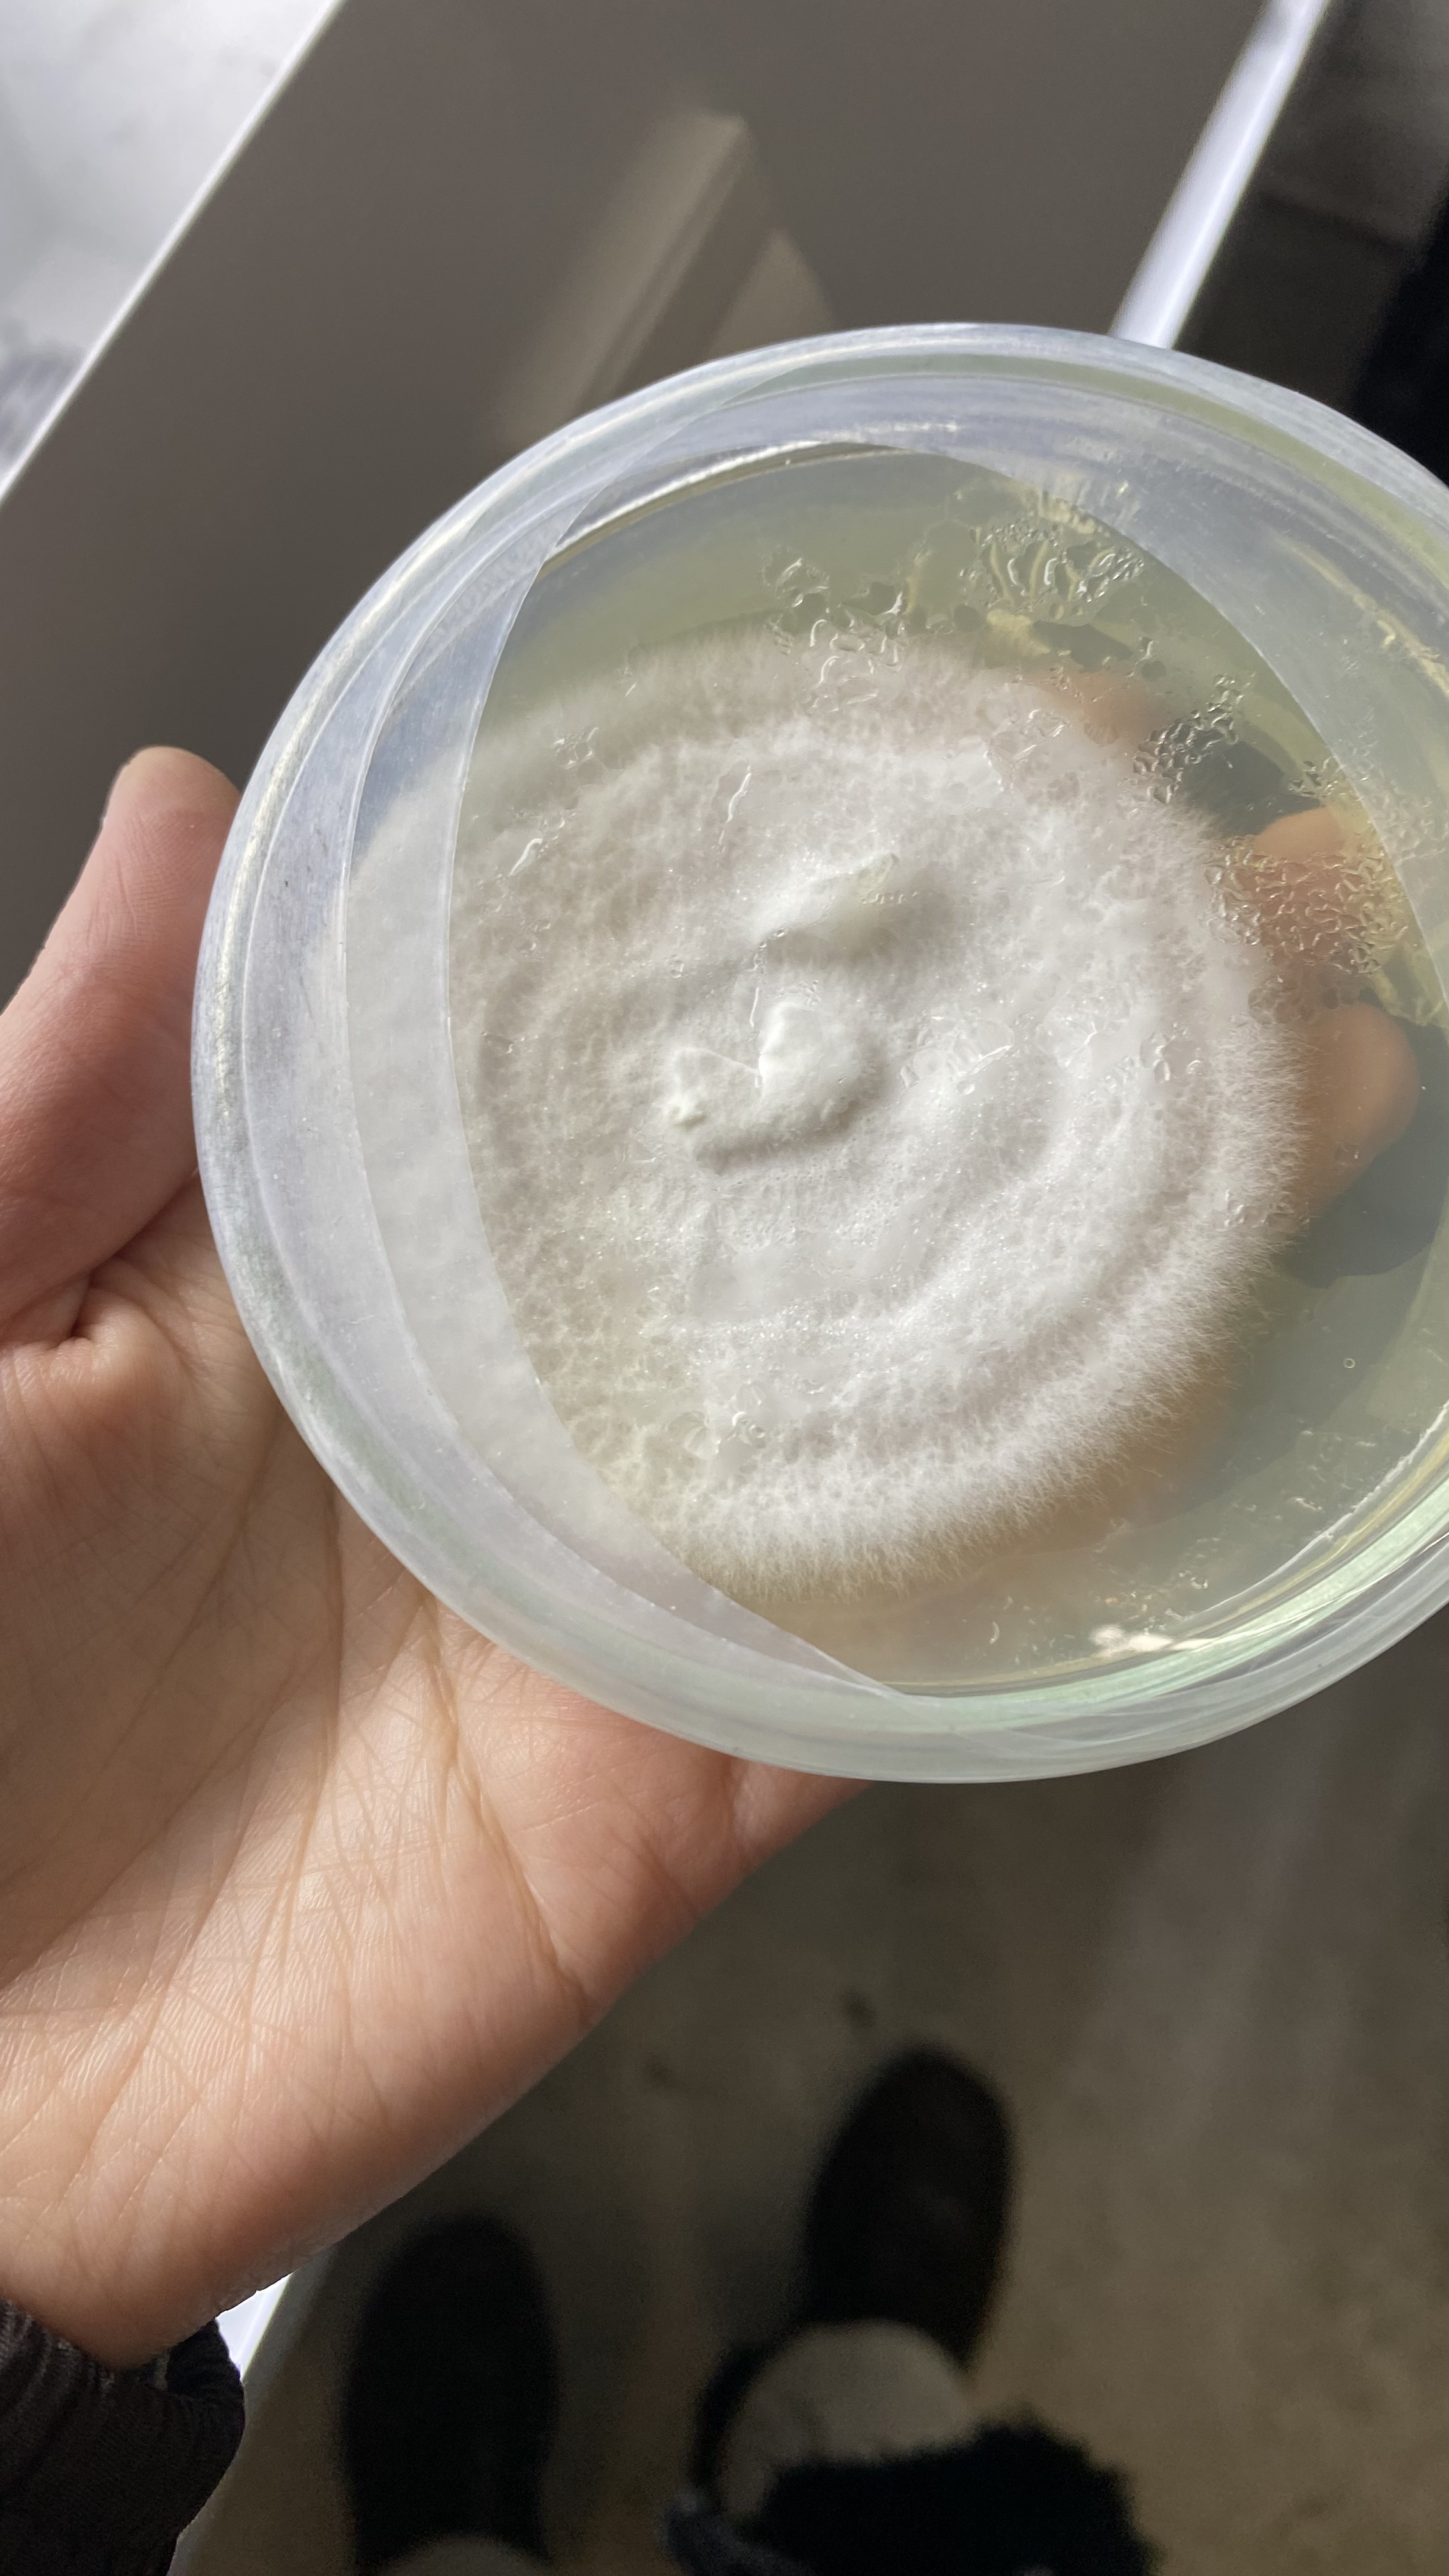
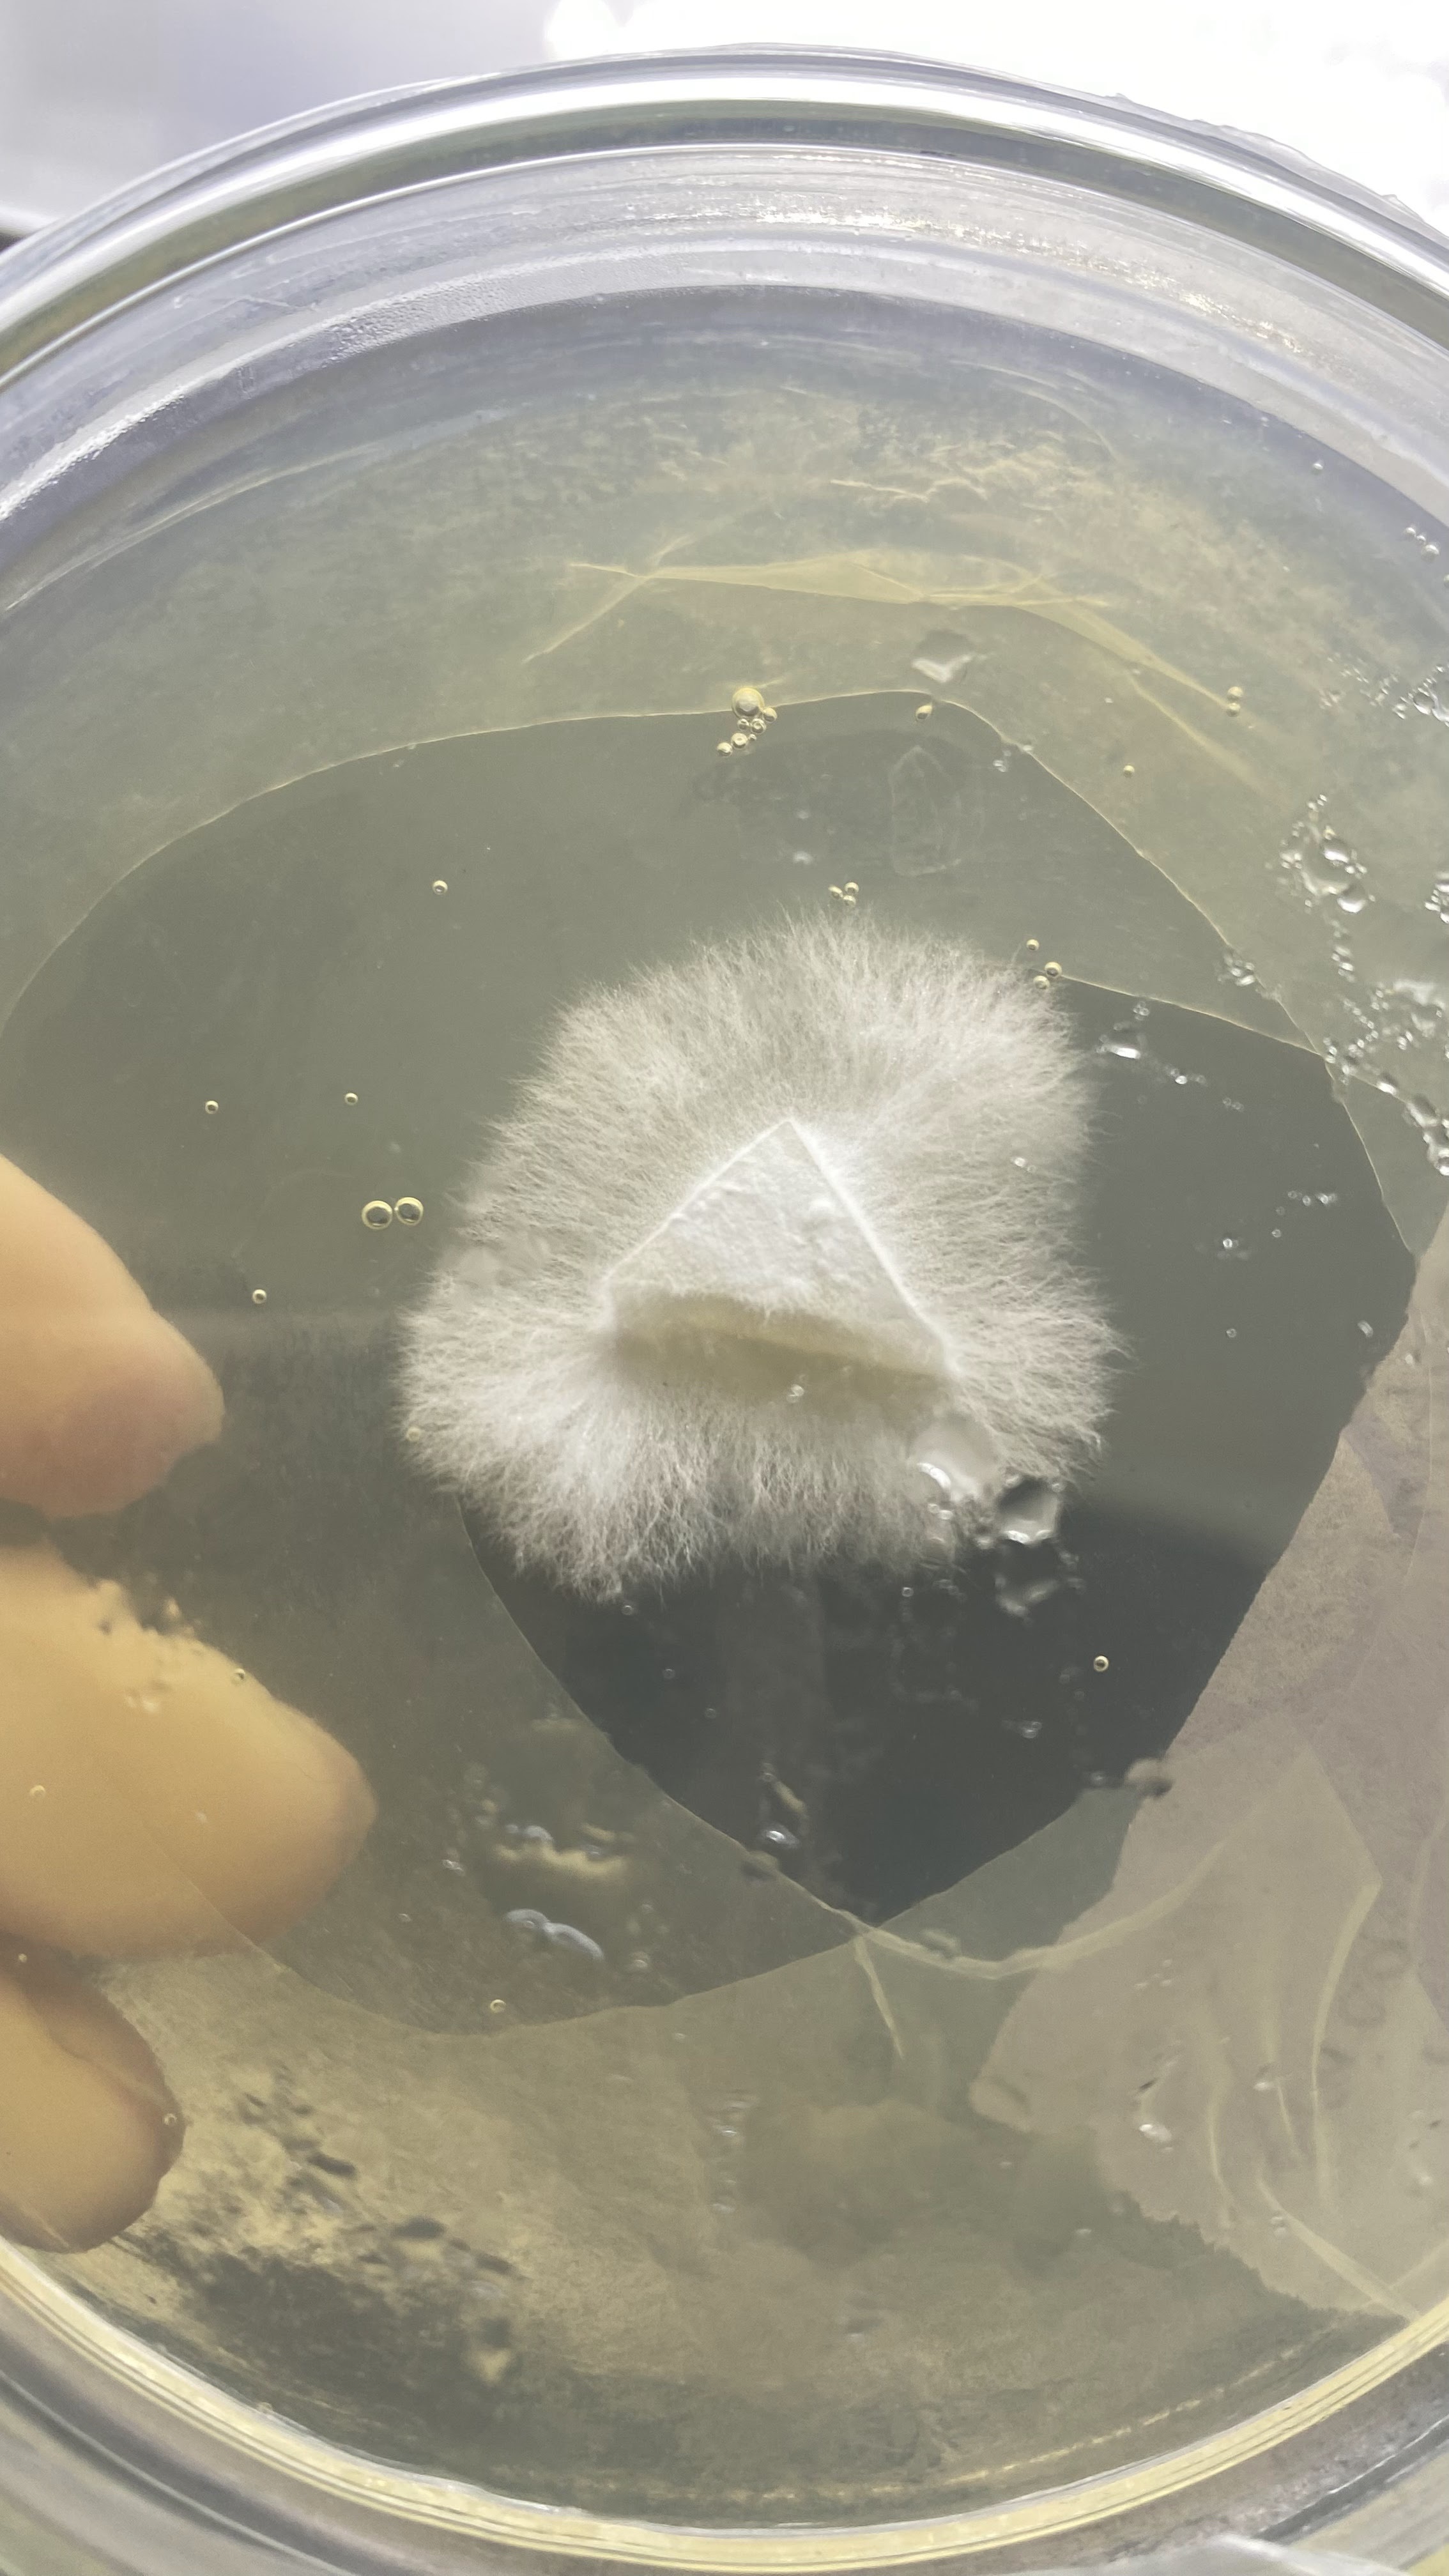

Hi, love
I'm Alisa Khvylia (she/it), Ukrainian off-disciplinary artist & biodesigner,
and graphic designer.
Currently I'm located in Kyiv, Ukraine.
All my CV / Portfolios may be found below.
For contact –alisakhvylia@gmail.com

Mycelium – vegetative or root-like structure of mushrooms.
Mycelium is used for packaging, clothes creation etc.
*Biomaterials or biodegradable materials – substances that naturally break down over time into non-toxic components through the action of microorganisms such as bacteria and fungi.
*Biomaterials or biodegradable materials – substances that naturally break down over time into non-toxic components through the action of microorganisms such as bacteria and fungi.






Bioyarn – a sustainable textile material made from biological sources like algae
Bioplastic – a type of plastic that can be broken down by microorganisms into natural components like water
SCOBY – a Symbiotic Culture of Bacteria and Yeast that is the living starter used to ferment sweet tea into kombucha
I work as biodesigner at HOPE • HOME Fungi Lab but I'm also open to commercial propositions, collabs etc. as an independent biodesigner.
.
If you have an idea for cooperations in mind – please, feel welcome to reach me out via email alisakhvylia@gmail.com
Below you can find types of biomaterials I work with.













